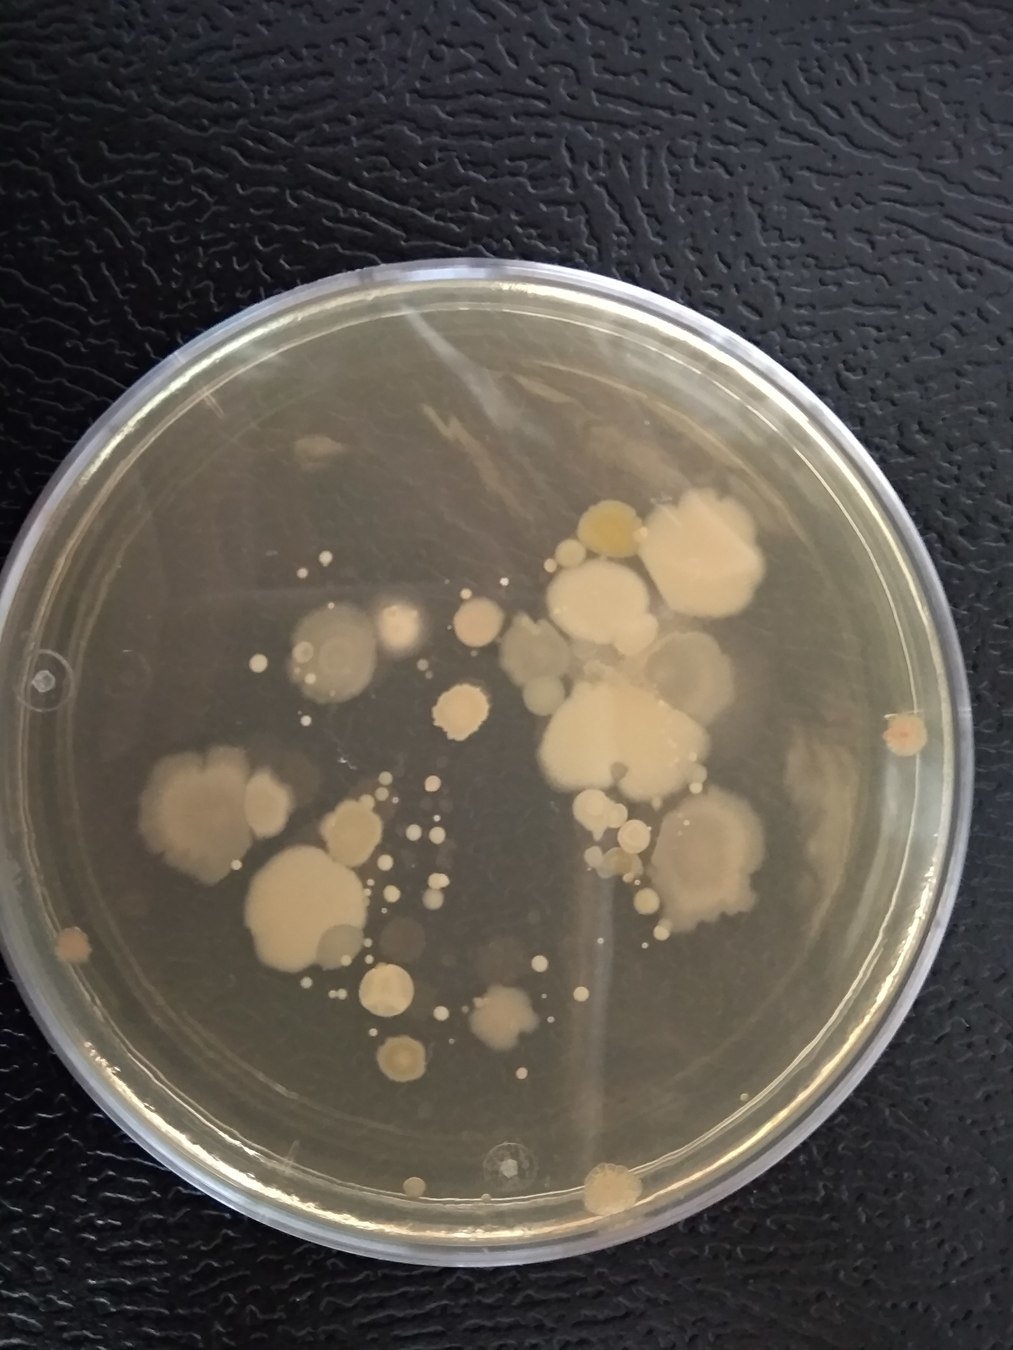
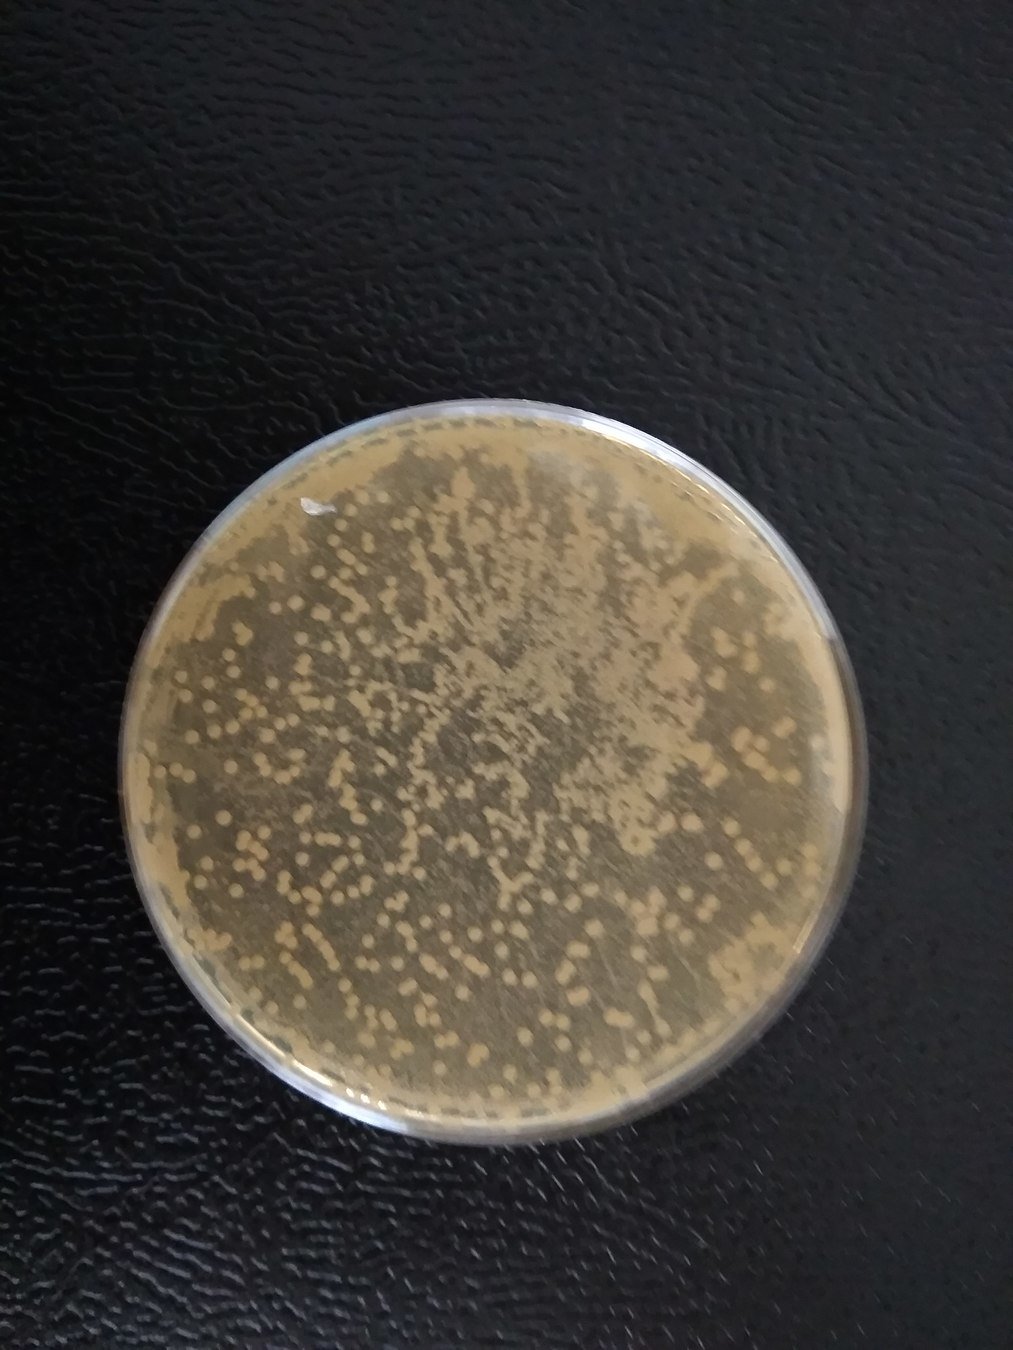
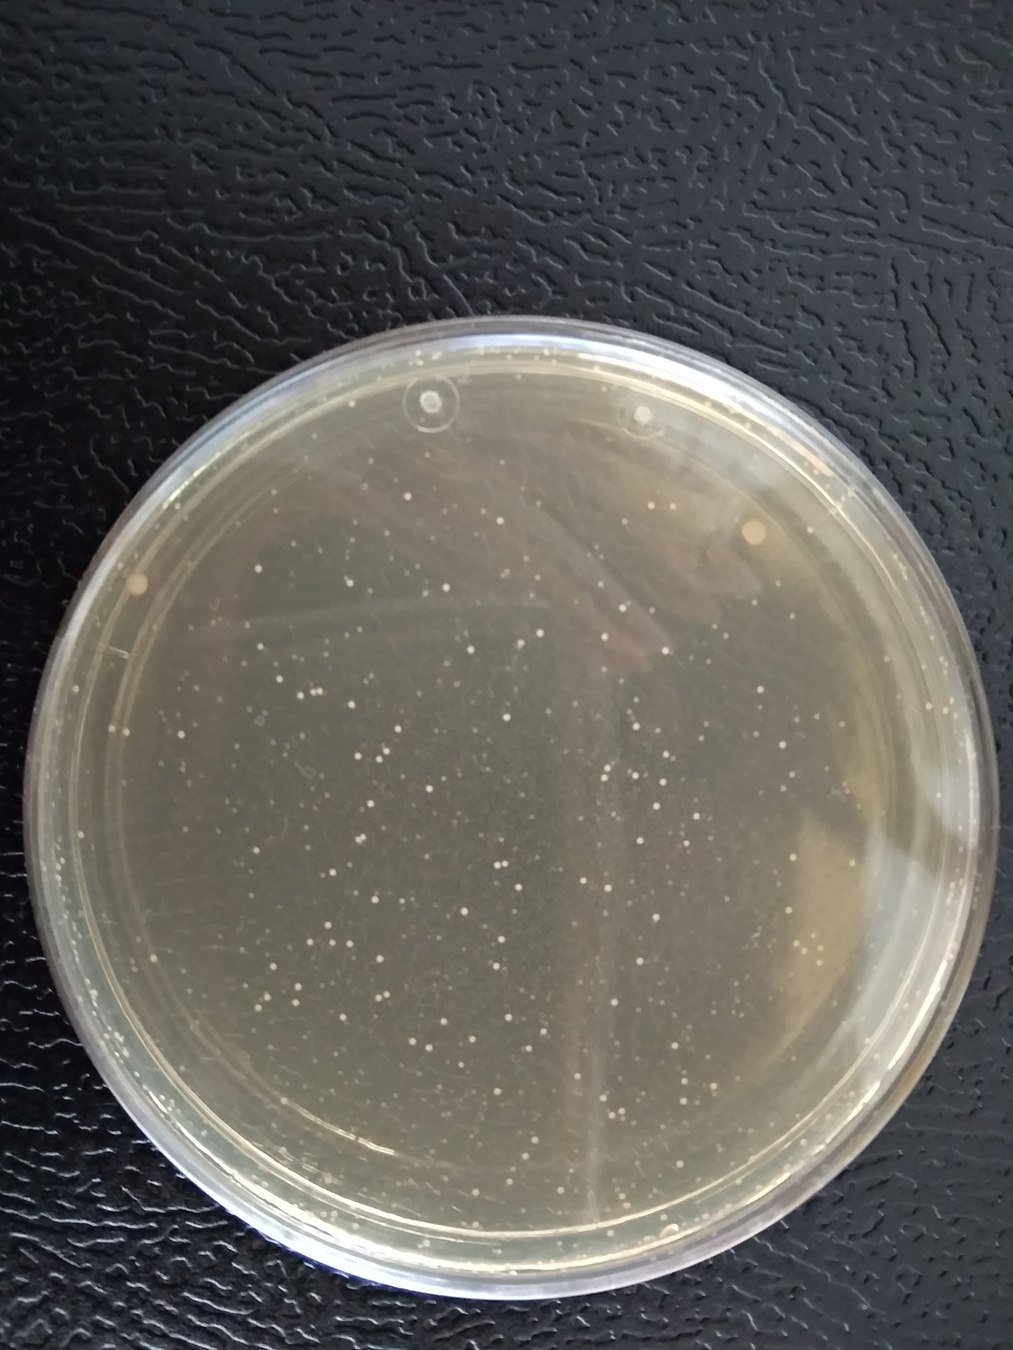

BACTERIA EVOLVE, SCIENCE TOO!




Open Science
Results in a more transparent, more verifiable, faster, more efficient, more reproducible and more sustainable research process
Open science increases innovative capacity.
People in our society can readily gain access to, and use, scientific information.
Our project
Maths
Computer Science
Biology
Proposes the problem and the experiments
Translate the problem. Create a theory to predict.
Produce results and simulations. Automatize the process
Our Project



Bacteria culture manual
Visual recognition of colonies
Mathematical models in 3D
Web App
One of the first social/collaborative app exclusively made for sharing not only knowledge, but true experiments
University dtps., social science, research group, open labs, etc

User-friendly for everyone!
Science Communication





Now to the
DEMO
Biological issues
Biological issues, progress properly

Biological issues, diluwhat?
Biological issues, the revenge

Mental Abuse To Humans



Mental Abuse To Humans
Fisher-Kolmogorov-Petrovsky-Piscounov

Mental Abuse To Humans
Sky is the limit
A lot has been done... But more exciting things await us
New models
New areas
Precise statistics prediction
Our own hardware
Global Database
Full automation
Live follow process
Sky is the limit

Sky is the limit

Impaciencia

Impaciencia
Text




A lot of work...
...and fun!!
Impaciencia



Impaciencia


We won!!
Impaciencia
Teamwork
Scientific divulgation
Open Science
Interdisciplinarity
Open source
Thanks!
Don't forget to subscribe!

@TheOpenBacteria
theopenbacteriaproject



